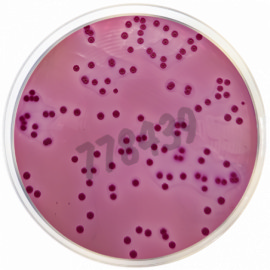
Milieu déshydraté pour gelose violet red bile avec

Milieux de bactériologie et additifs
4723 produits - Trié par pertinence
Milieu préparé en tube bouilllon soja rappaport 20 tubes
Réf. UGAP : 3658766 Réf. constructeur : 4245
Peptone de viande digestion enzymatique pour biotechnologies 5 kg
Réf. UGAP : 3735941 Réf. constructeur : 82962-5KG-F
Supplément selective listeria modifiee formulation qsp 500ml chacun 10 flacons
Réf. UGAP : 3658820 Réf. constructeur : 6003